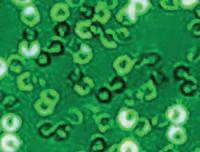
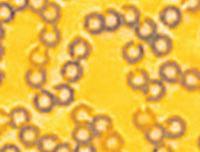
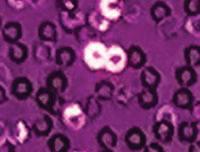
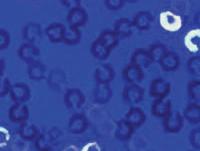

See something you love? Use our new virtual design tool uDesign ® to see it in your colors before you buy! It's so easy! Just scan the QR code and go right to our site to start designing, view pricing and shipping times, and place your order.

Somerset Academy 2022 WGI Scholastic A Class Champion




Four different silhouettes available













Don't forget the QR code! Order online, view pricing, fabrics & ship time.




































 Skirt sold separately
Skirt sold separately





























































Pants sold separately


Pants sold separately
Pants sold separately






















Don't forget the QR code! Order online, view pricing, fabrics & ship time.














































Cape sold separately













































































Choose your favorite silhouette. Then add a print!







Don't forget the QR code! Order online, view pricing, fabrics & ship time.






















































Mock turtleneck long sleeve asymmetrical tunic available in holographic silver or gold.



$69.99

Tunic top with elegant mesh long sleeves. Keyhole back and side slit for the perfect fit. Mystique chest stripe, mock turtleneck and cuffs in red or royal.


$69.99




Vivace tunic top with crew neck, long sleeve, asymmetrical empire waist. Accompanying male short sleeve crew neck top available.














Available in 7 micro sequin colors. See page 93 for color swatches.
Choose from:
• Black
• Gold
• Kelly Green
• Orange
• Red

• Royal
• Silver
Sleeveless tunic top in your choice of select micro sequin chest inset.


$59.99
Short sleeve male top in your choice of select micro sequin inset.
$59.99

Classic and irresistible made current! Asymmetrical mock turtleneck tunic top with keyhole front. Available in your choice of ultra sequin chest inset and mystique binding.


$69.99

Available in 7 ultra sequin colors. See page 93 for color swatches.
Choose from:
• Black
• Gold
• Kelly Green
• Orange
• Red

• Royal
• Silver
Shop


CALL TO ORDER! 800.458.2549
Gold or silver ultra sequin dress with mystique trunks. Includes two different personalization style options:


1.) Bowtie two-color twill lettering (max 7 letters) with one large background initial
$169.99
Gold or silver ultra sequin dress with mystique trunks in your choice of sequin trim.



$159.99
Black or white full sleeve leo with zipper back. Sequin trim patterns available in your choice of colors.

$109.99
Rhinestones available for additional cost and production time.

Shop



Black print with your choice of 14 different accent colors. See page 89 for color swatches.

Choose from:
• Azure
• Cabernet
• Coal Black
• Deep Sea
• Fire
• Forest
• Irish
• Lemon

• Majestic
• Nightshift
• Optic

• Putty
• Sunshine
• Surf

6 PIECE MINIMUM


















Full
SKU VIV-HOOD-2301


Price: $59.95 / Custom: $79.95
Twelve fun styles available! Choose from select patterns and colors or create a fully custom look for the entire team.





• 4 standard pattern options
• 14 standard color options
• 3 standard font options
• 6-piece minimum order
• 6 weeks production time (Additional 2 weeks for custom)
Crewneck T-Shirt
SKU VIV-SHRT-2301
Price: $32.95 / Custom: $39.95
Paneled
SKU VIV-JCKT-2301
Price: $54.95 / Custom: $74.95
Jacket

SKU VIV-JCKT-2302
Price: $54.95 / Custom: $74.95
Jogger
SKU VIV-PANT-2301

Price: $43.95 / Custom: $49.95
V-Neck T-Shirt



SKU VIV-SHRT-2302
Price: $32.95 / Custom: $39.95
Leggings

SKU VIV-PANT-2302

Price: $43.95 / Custom: $49.95
Paneled Shorts


SKU VIV-SHOR-2302
Price: $32.95 / Custom: $39.95
Zipper Hoodie Sweatpants Jacket















Measure around the full part and keep your tape close under the arms and across, not under, the shoulder blade.
B. Waist
Measure at the narrowest point.
C. Hips
Stand straight with your heels together and keep the tape parallel to the floor as you measure around the fullest part.
D. Girth
Measure from the center of right shoulder, down the front, through the crotch and up the back to the center of the left shoulder.
• To ensure accuracy, never measure yourself.
• Measure over the undergarments you normally wear when performing, NOT over street clothes.

• Keep measuring tape straight and snug, but not tight. Don’t add or subtract inches.
• Locate the measurements that most closely match yours. Not all measurements will be exact.






• Girth is most important.





Embellish your look for extra sparkle! Available on all costumes for additional cost and production time. 12-piece minimum. Call 800.458.2549 to get started.




























































 Black
Black
Black
Black Bright Gold
Brown
Bright Silver
Brown
Forest Green
Columbia Blue
Forest Green
Grey Copper
Red Grey Tan
Kelly Green
Dark Red
Royal Blue
Maroon
White
Maroon Gold Silver
Navy Blue
Forest Green Gold
Hot Pink
Lime Green Kelly Green
Maroon
Navy Blue
Gunmetal
White Pearl
Nude
Navy Blue Orange
Purple
Kelly Green
Orange
Red
Navy Blue
Purple
Royal Blue Orange Red
Purple Red Silver Royal Blue White White
Purple
Royal Blue
Black
Black
Black
Black Bright Gold
Brown
Bright Silver
Brown
Forest Green
Columbia Blue
Forest Green
Grey Copper
Red Grey Tan
Kelly Green
Dark Red
Royal Blue
Maroon
White
Maroon Gold Silver
Navy Blue
Forest Green Gold
Hot Pink
Lime Green Kelly Green
Maroon
Navy Blue
Gunmetal
White Pearl
Nude
Navy Blue Orange
Purple
Kelly Green
Orange
Red
Navy Blue
Purple
Royal Blue Orange Red
Purple Red Silver Royal Blue White White
Purple
Royal Blue

Black
Black Holo Burgundy Columbia Blue
Gold Forest Green Royal Blue
Kelly Green Holo Turquoise Holo White
Navy Blue Holo
Gold Silver
Orange Holo
Kelly Green White
Purple Holo
Navy Blue
Red Holo Orange
Royal Blue Holo Purple
Silver Holo Red
Black Brown Columbia Blue Gold Gunmetal Kelly Green
Silver Spotlight
Maroon
Navy Blue Turquoise
Orange White
Pure Purple Yellow
Red Purple Grape Royal Blue
Gold Spotlight Silver Spotlight
Black
Black Holo Burgundy Columbia Blue
Gold Forest Green Royal Blue
Kelly Green Holo Turquoise Holo White
Navy Blue Holo
Gold Silver
Orange Holo
Kelly Green White
Purple Holo
Navy Blue
Red Holo Orange
Royal Blue Holo Purple
Silver Holo Red
Black Brown Columbia Blue Gold Gunmetal Kelly Green
Silver Spotlight
Maroon
Navy Blue Turquoise
Orange White
Pure Purple Yellow
Red Purple Grape Royal Blue
Gold Spotlight Silver Spotlight







